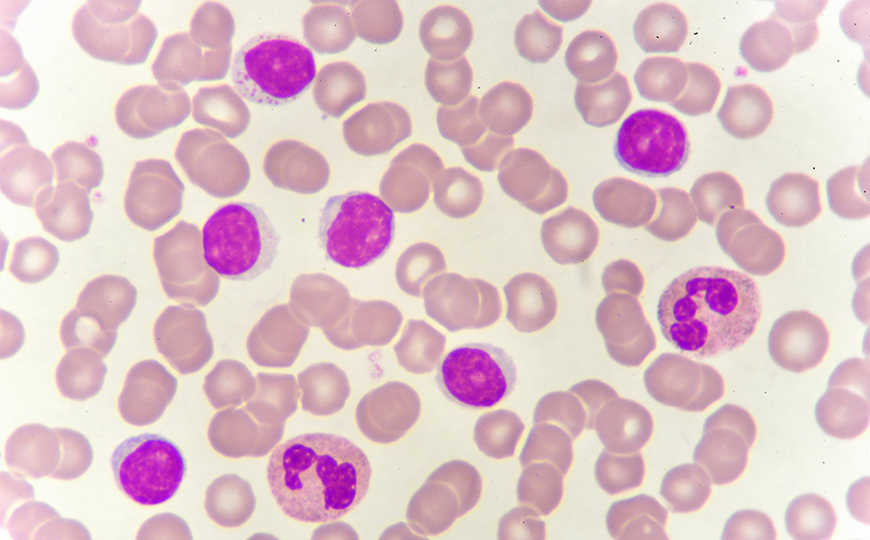

Найдены генетические варианты, связанные с уровнями лейкоцитов и аллергией
Исследование, в котором приняли участие более 61 800 человек различного происхождения, выявил новые генетические локусы, ассоциированные с характеристиками лейкоцитов крови. Например, распространенная у афроамериканцев вариация в некодирующей области между генами CSF2RA и CLRF2 коррелировала со сниженным уровнем эозинофилов и устойчивостью к аллергии.
В рамках программы TOPMed международная исследовательская группа проанализировала данные глубокого секвенирования геномов 61 802 человек. В выборку вошли примерно 33 300 американцев европейского происхождения, более 14 200 человек афроамериканского происхождения, 686 выходцев из Восточной Азии и почти 13 600 латиноамериканцев. Авторы также измерили параметры проб крови испытуемых. Целью работы было выявление генетических вариантов, ассоциированных с гематологическими признаками. Это первое подобное исследование, охватывающее большое разнообразие популяций.
Ученые обнаружили 109 563 748 однонуклеотидных вариаций и небольших вставок или делеций. Полученные данные использовались для поиска генетических ассоциаций с шестью показателями проб крови (в работе они названы фенотипами): концентрации базофилов, эозинофилов, нейтрофилов, лимфоцитов, моноцитов и общее количество лейкоцитов.
Для определения связи генетических вариантов с количественными признаками авторы использовали двухуровневую смешанную линейную модель. На первом этапе они оценили взаимодействия вариантов с полом, происхождением человека и прочими факторами, не связанными с таргетными фенотипами. Модель строилась на основе гипотезы, что ассоциаций между генетическими вариантами и этими параметрами нет. На втором этапе авторы использовали результаты первой модели, чтобы получить только ассоциации, которые напрямую связаны с таргетными признаками. Подробнее про смешанные модели можно посмотреть, например, здесь.
Используя смешанные линейные модели и еще ряд статистических тестов, ученые определили 165 ассоциаций генетических вариантов с количеством лейкоцитов. Из них 18 они выделили как важные, в том числе семь новых локусов внутри или вокруг генов CSF2RA, HBB, NRIP1, S1PR3, OPCML и NPHP3.
Так, в некодирующей последовательности псевдоаутосомной области Х-хромосомы, между генами CSF2RA и CLRF2, ученые обнаружили вариант, особенно распространенный среди афроамериканцев. Он был ассоциирован со сниженным уровнем эозинофилов в крови и повышенной устойчивостью к астме и атопическому дерматиту. Это согласуется с более ранними исследованиями, где было показано, что снижение эозинофилов связано с меньшей вероятностью аллергии.
Редкие варианты генов FLT3 и TET2 были ассоциированы с количеством моноцитов, возникновением и развитием лейкоза и клональной экспансией миелоидных клеток. Варианты гена S1PR3 на хромосоме 9, по-видимому, связаны с количеством моноцитов у афроамериканцев, в то время как миссенс-мутация в гене HBB хромосомы 11 ассоциировалась у них со снижением количества лимфоцитов и серповидно-клеточной анемией.
Эти и другие результаты работы подчеркивают важность полногеномного секвенирования больших выборок, в которых присутствуют люди различного происхождения, для выявления ассоциаций, которые были упущены в GWAS для европейских когорт.
Источники
Anna V. Mikhaylova et al. Whole-genome sequencing in diverse subjects identifies genetic correlates of leukocyte traits: The NHLBI TOPMed program // The American Journal of Human Genetics (2021); DOI: 10.1016/j.ajhg.2021.08.007
New Leukocyte-Linked Loci Uncovered With Multi-Ancestry Genomes


 Меню
Меню





 Все темы
Все темы




 0
0












